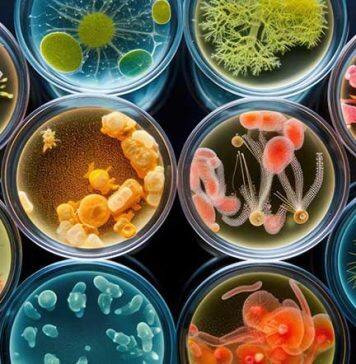
$2m funding boost for innovative health and medical projects

Carbon removal project aims to improve livelihoods in Vietnam
The University of Adelaide is a partner in a project to establish a facility in Vietnam’s Mekong Delta to turn waste biomass from agricultural activities into biochar.
Stanford study finds climate warnings in ancient seas
A fossil study from Stanford University finds the diversity of life in the world’s oceans declined time and again over the past 145 million years during periods of extreme warming.
CS4HS open to more digital teachers
The Covid omicron outbreak has proven to be a blessing in disguise for 2022’s CS4HS workshop, which takes place online on Thursday 10 February, as it will now be able to host even more teachers from throughout New Zealand.
Melsonby Hoard saved for the nation
One of the UK’s largest and most important Iron Age finds – excavated by archaeologists at Durham University – has been saved for the nation.
Doctor secures national scholarship to explore AI goals
A medical doctor with an interest in artificial intelligence, who is also a University of Adelaide alum, has been awarded one of the prestigious 2024 General Sir John Monash Scholarships.
Claims less Aussies paying tax not backed by data
No, there's not an increasing number of Australians freeloading off other taxpayers. A new ANU study explains why -- with a little help from the cult film, The Princess Bride.
St Andrews holds top spot in Scotland in Complete University Guide
The University of St Andrews has once again claimed the top spot in Scotland and secured its place among the UK’s leading higher education institutions...
UC VC invited to speak at Oxford University
As part of marking her university’s 150th anniversary, UC Tumu Whakarae | Vice-Chancellor Professor Cheryl de la Rey has given a speech at Christ Church Cathedral, Oxford University, England.
McMaster student-led startup working to solve emergency room triage delays
A McMaster student-led startup is working on solving the problem of delays in emergency room triage, starting with hospitals in Ontario.
UNSW medicine graduate awarded NSW Rhodes Scholarship
Dr Ragavi Jeyakumar is passionate about health equity and will work towards making Australia’s health system fairer and more accessible.